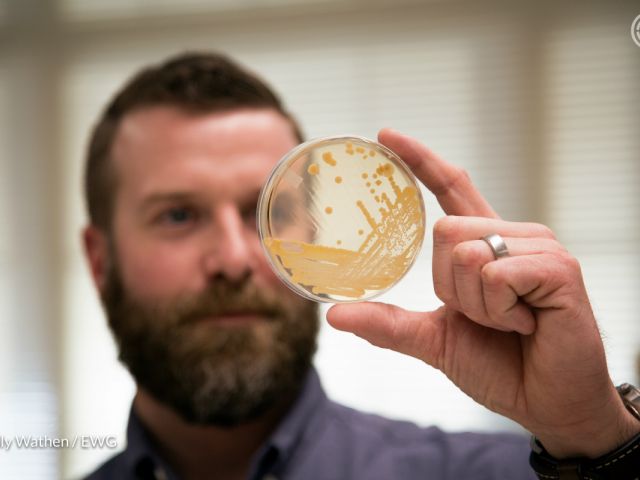

Displaying 409 - 432 of 7921
“Obamacare” of Crop Insurance? Not Exactly.
Rep. Kevin Cramer (R-ND) will oppose a budget deal because $3 billion in savings come at the expense of giant crop insurance companies. In his statement, Rep. Cramer called a proposal to limit...

Nitrate pollution plagues Midwestern rivers
A recent study by scientists at the U.S. Geological Survey has concluded that the water quality in 22 rivers over the past 65 years is terrible and not getting better, judging by the concentration of...

Infants' Exposure to Toxic Fire Retardant Linked to Baby Items
Evidence of a chemical linked to cancer and hormone disruption was found in the urine of all babies tested for a new study from Duke University. The sources, researchers say, could be nursery gliders...

Time to Lift the Veil of Secrecy from the Crop Insurance Program
The head of the crop insurance industry's trade group is objecting to an EWG analysis that found that crop insurance companies could easily absorb cuts to their taxpayer-guaranteed rate of return. But...

Common Preservative in Personal Care Products Linked to Breast Cancer
Low levels of chemical preservatives widely used in cosmetics, shampoos, skin lotions and other personal care products may be linked to breast cancer, according to a new study from researchers at the...

Looking for the Perfect Cosmetics Gift Box? Shop Smarter with EWG’s Skin Deep
Every holiday shopping season, stores nationwide offer deals on a wide assortment of fragrance and cosmetics gift sets. Nearly every major retailer, from the high-end department store to the...

Top Problems With the Two TSCA Bills
Consumers rightly expect that the chemicals used in everyday products are safe. Under current law, however, few are ever reviewed for safety.

‘Retired’ Sensitive Cropland: Here Today, Gone Tomorrow?

Kudos to Companies Pledging to “Remove” ADA
In the ensuing furor other producers of commercial baked goods said they too were abandoning ADA.

EWG’s Top 10 Enviroblog stories of 2015
The EWG staff voted the landmark global climate accord approved on December 12 in Paris as the top environmental story of 2015. In our judgment, the achievement of the Paris pact is that, for the...

Insurance by Any Other Name…?
Like most Americans, I have firsthand experience on how insurance is supposed to work. I've had auto insurance since the end of high school when I got the keys to my first car. And I've paid for...

Obama Offers $18 Billion Fix to Bloated Crop Insurance Program
This week, President Obama released a 2017 fiscal year budget proposal that would save taxpayers more than $18 billion and better protect America's land and water.

Here Today, Gone Tomorrow
We're fooling ourselves if we think that voluntary conservation efforts are going to solve the Corn Belt's dirty water problems.
What the elephant knows about cancer prevention
Elephants are less likely to get cancer than humans, even though they have many more cells. Why? Teams of scientists from the University of Utah and the University of Chicago have separately concluded...

Cancer and the Environment: 10 Common Misconceptions Answered
As a cancer epidemiologist, I've spent a lot of time researching the links between environmental contaminants and cancer. One of the pitfalls of the Digital Age is that people come across a lot of...

Science For Sale: Ford Spends $40M to Discredit Danger of Asbestos Brakes
In 1971 Ford Motor Company decided that $1.25 per car was too much to spend on safer alternatives to asbestos brakes. Thirty years later, in the face of mounting lawsuits, Ford began spending millions...

Corn Lobby’s GMO Labeling Study “Preposterous”
Labeling food that contains genetically engineered, or “GMO,” ingredients will not cost the preposterous $81.9 billion that the corn industry claims. The new study – paid for by the Corn Refiners...

Is Federal Crop Insurance Policy Leading to Another Dust Bowl?
Is Federal Crop Insurance Policy Leading to Another Dust Bowl?

Rep. Pallone Seeks Answers on Alleged Hair Loss by Users of WEN Cleansing Conditioner
Rep. Frank Pallone, Jr., of New Jersey, the highest-ranking Democrat on the House Energy and Commerce Committee, is seeking answers for why more than 17,000 Americans have complained of hair loss and...

GMO Lobster? GMO Bacon?
More meat and fish from genetically engineered animals could be coming to your dinner plate.

Exposing Fields of Filth

Farm Subsidies Will Cost Taxpayers Some Serious Cheese
You may have thought that the $20 million “cheese bailout” was the biggest news in farm policy this week, but you'd be wrong.

Dangerous Monsanto Chemical Remains in Thousands of Schools

Ask an Expert: Your Questions Answered by Curt DellaValle, Ph.D., Senior Scientist
